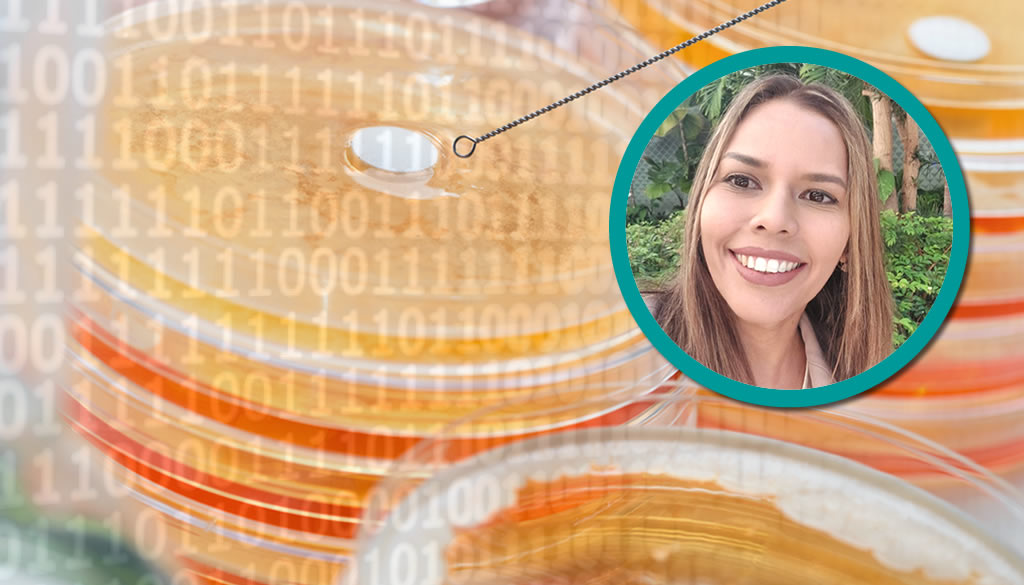

Especialistas impulsan protocolo de higiene de la herida como estrategia para combatir la Resistencia Antimicrobiana

La Asociación Dominicana para el Manejo Holístico de Heridas y Ostomías (ADOHER) realizó un taller de actualización sobre manejo integral de heridas y ostomías, donde especialistas destacaron que la eliminación del biofilm es fundamental para reducir el uso innecesario de antibióticos en heridas de difícil cicatrización. Durante el encuentro se explicó que la mayoría de […]
Infectólogos alertan sobre preocupante aumento de resistencia antimicrobiana en RD

La Sociedad Dominicana de Infectología (SDI) manifestó su preocupación ante el incremento de la resistencia antimicrobiana en el país, reflejado en el boletín epidemiológico más reciente de la Dirección General de Epidemiología, el cual reporta un aumento significativo de bacterias resistentes en los últimos años, entre ellas Klebsiella spp., Pseudomonas aeruginosa y Staphylococcus aureus, incluyendo […]
Colegio de Cirujanos Filial Este invita a jornada sobre resistencia antimicrobiana

El Colegio Dominicano de Cirujanos Filial Este, la Sociedad Dominicana de Infectología y la Asociación Dominicana para el Manejo Holístico de Heridas y Ostomías (ADOHER) anunciaron la realización de la jornada académica “Unidos contra la Resistencia Antimicrobiana”, un encuentro dirigido a profesionales de la salud con el propósito de promover el uso racional de antibióticos […]
Alerta: informe revela incremento de la resistencia a antibióticos esenciales

Un nuevo informe de la Organización Mundial de la Salud (OMS) reveló que de cada seis infecciones bacterianas confirmadas por laboratorio, causantes de infecciones comunes en personas a nivel mundial en 2023, fue resistente a los tratamientos con antibióticos. La evidencia demuestra que entre 2018 y 2023, la resistencia a los antibióticos aumentó en más […]
Descubren «memoria mecánica» en bacterias E. coli clave que ayuda a comprender resistencia a los antibióticos

Investigadores del Instituto de Biología Integrativa de Sistemas (I2SysBio), centro mixto del CSIC y la Universitat de València, han identificado una “memoria mecánica” en bacterias Escherichia coli que permite comprender mejor cómo estas sobreviven a la acción de los antibióticos. El hallazgo, publicado en la revista Nature Communications, revela que las fuerzas físicas y la […]
Alertan resistencia bacteriana ya está en los ríos del país

La Sociedad Dominicana de Infectología expresó su preocupación ante los recientes hallazgos del Instituto de Innovación en Biotecnología e Industria (IIBI) y universidades aliadas como COMONIINTEC, ISFODOSU e ISA, quienes mediante análisis genómico avanzado detectaron la presencia de bacterias resistentes a antibióticos en ríos importantes de la República Dominicana. Entre los ríos afectados se encuentran […]
Investigadores crean base de datos y un software para combatir la resistencia de los hongos a los medicamentos

Un equipo internacional liderado por el Instituto de Biología Funcional y Genómica (IBFG, CSIC–USAL), en colaboración con la Universidad de Salamanca y la Université Laval (Canadá), ha creado FungAMR, la mayor base de datos existente sobre mutaciones que confieren resistencia a antifúngicos. La herramienta recopila más de 50.000 registros y 35.000 mutaciones en 95 especies […]
Estudio alerta sobre el impacto clínico de la resistencia a la amoxicilina en neumonía neumocócica invasiva

Un equipo de investigadores del Instituto de Investigación Biomédica de Bellvitge (IDIBELL), el Hospital Universitario de Bellvitge y el CIBER de enfermedades respiratorias (CIBERES) ha publicado un estudio que pone en evidencia los riesgos asociados a la resistencia a la amoxicilina en casos de neumonía neumocócica invasiva. La investigación, que ha sido destacada como Editor’s […]
Investigación en tuberculosis: la lucha contra la resistencia antimicrobiana

La tuberculosis, una enfermedad infecciosa causada por la bacteria Mycobacterium tuberculosis, sigue siendo la principal causa de muerte por infección a nivel mundial, según la Organización Mundial de la Salud (OMS). A pesar de contar con tratamientos antibióticos eficaces, el aumento de la resistencia antimicrobiana representa un desafío creciente para la salud global. Un problema […]
Semana de la Concienciación sobre la resistencia a los antimicrobianos

18-24 de Noviembre 2024 Educar. Promover. Actuar ahora. Por: Dra. Rosa Abreu, presidenta SDI La resistencia a los antimicrobianos surge cuando las bacterias, los virus, los hongos y los parásitos cambian a lo largo del tiempo y dejan de responder a los medicamentos, lo que hace más difícil el tratamiento de las infecciones e incrementa […]
Alertan impacto de resistencia antimicrobiana en reducción esperanza de vida

La resistencia a los antimicrobianos (RAM) amenaza con reducir la esperanza de vida global a 1,8 años para el 2050, así lo advirtió la Organización Mundial de la Salud (OMS). En 2019, se registraron cerca de cinco millones de muertes relacionadas con infecciones bacterianas resistentes a los medicamentos y 1,27 millones de personas fallecieron directamente […]
Entidades firman acuerdo para combatir resistencia a los antibióticos en América Latina y el Caribe

La Organización Panamericana de la Salud (OPS) y la Global Antibiotic Research & Development Partnership (GARDP) han firmado un importante acuerdo de colaboración para hacer frente a la creciente amenaza de la resistencia a los antimicrobianos (RAM) en América Latina y el Caribe. Esta alianza busca fortalecer la investigación, el desarrollo, la producción y el […]
Ministro de Salud destaca necesidad redoblar esfuerzos frente a resistencia antimicrobiana

El ministro de Salud, doctor Víctor Atallah destacó que la resistencia antimicrobiana no es solo un desafío sanitario, sino una amenaza global a la seguridad y al desarrollo humano que podría convertirse en una próxima gran pandemia, sino se asumen acciones a nivel internacional, regional y nacional coordinadas y coherentes. El funcionario indicó que la […]
Advierten resistencia a antimicrobianos amenaza con revertir décadas de avances médicos

La Organización Mundial de la Salud (OMS) llamó a los líderes mundiales a la adopción de medidas urgentes de alto nivel para enfrentar los desafíos críticos relacionados al flagelo mundial de la resistencia a los antimicrobianos (RAM). Durante la semana de alto nivel de la 79ª Asamblea General de las Naciones Unidas (UNGA79) la OMS […]
Contaminación del aire y resistencia a antibióticos: un doble reto global que provoca millones de muertes

Un estudio reciente realizado por investigadores del IDIBELL, el Hospital de Bellvitge, el CIBERINFEC y el CIBERESP ha revelado por primera vez que la contaminación del aire se asocia directamente con un aumento en el consumo de antibióticos. Publicado en la revista JAMA Network Open, el estudio analizó datos de contaminación y prescripción de antimicrobianos […]
Revelan impacto análisis de datos en lucha contra farmacorresistencia
En el contexto actual, donde la resistencia a los antibióticos constituye una creciente amenaza para la salud pública, el análisis de datos y la epidemiología digital se perfilan como herramientas vitales para la detección de patrones y prevención, transformando la lucha contra la farmacorresistencia. «La resistencia a los antimicrobianos no solo es un fenómeno natural, […]
